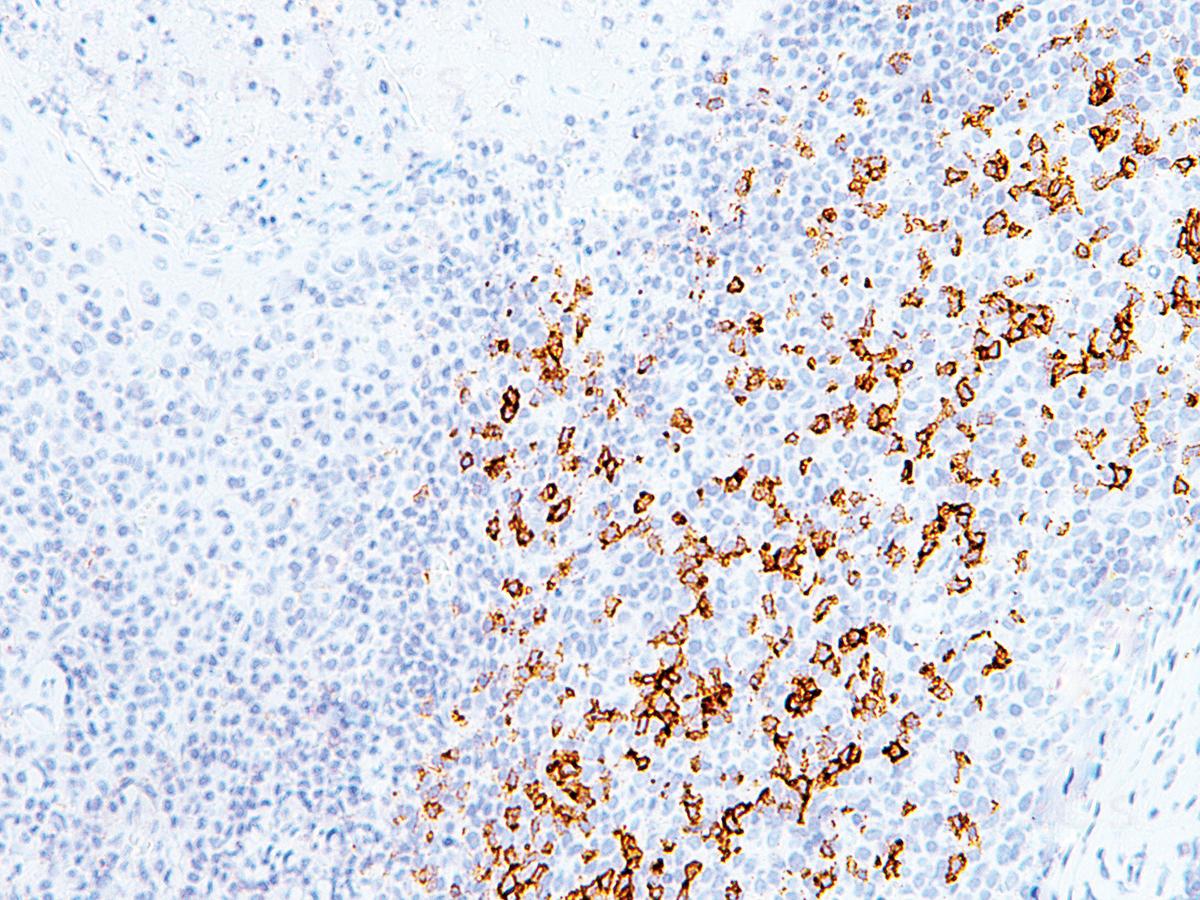

Anti-PD-1 Monoclonal Antibody (Clone:IHC001)
Shipping Info:
For estimated delivery dates, please contact us at [email protected]
| Format : | Purified |
| Amount : | 0.5 ml |
| Isotype : | Mouse IgG2b |
| Purification : | Protein A/G Chromatography |
| Content : | Tris Buffer, pH 7.3 - 7.7, with 1% BSA and <0.1% Sodium Azide |
| Storage condition : | Store at 2°C - 8°C. Do not freeze. |
Programmed Death 1 (PD-1) is a member of the CD28/CTLA-4 family of T-cell regulators, expressed as a co-receptor on the surface of activated T-cells, B-cells, and macrophages. New studies have suggested that the PD-1/PD-L1 signaling pathway may be linked to anti-tumor immunity, as PD-L1 has been shown to induce apoptosis of activated T cells or inhibit activity of cytotoxic T cells. In comparison to CD10 and Bcl-6, PD-1 is expressed by fewer B cells and has therefore been considered a more specific marker for angioimmunoblastic T-cell lymphoma. Therapies targeted toward the PD-1 receptor have shown remarkable clinical responses in patients with various types of cancer, including non–small-cell lung cancer, melanoma, and renal-cell cancer.
Recommended dilutions: Immunohistochemical analysis: 1:100 - 1:200. However, this need to be optimized based on the research applications.
For Research Use Only. Not for use in diagnostic/therapeutics procedures.
| Subcellular location: | Membrane |
| BioGrid: | 111160. 61 interactions. |
|
There are currently no product reviews
|

.png)











